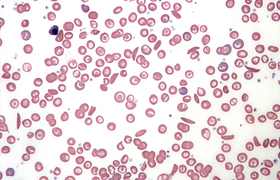

Alan Pifer Award: A hat-tip to geneticist Professor Ambroise Wonkam
03 August 2021 | Story Nobhongo Gxolo. Photo Je’nine May. Read time 7 min.
Growing up in Yaoundé, Cameroon, Professor Ambroise Wonkam pursued an atypical career path: medical research. Having decided early on in his education journey that he would follow an academic career, he thought one of the best ways to do this was through training in basic science. For him this meant exploring cell biology, which would end up being his gateway into genetics. An award-winning and world-renowned geneticist recognised for his work in sickle cell disease (SCD), he recently completed a three-year term as the Deputy Dean for Research (DDR) at the University of Cape Town’s (UCT) Faculty of Health Sciences (FHS). Professor Wonkam is one of two recipients of the 2020 Alan Pifer Award.
The prestigious award is the vice-chancellor’s annual prize in recognition of outstanding welfare-related research. Designed to encourage socially responsive research at UCT, the accolade honours researchers whose work is making a difference in the lives of disadvantaged communities in the country. This year, it is shared between Wonkam and Professor Cathy Ward in the Department of Psychology.
Wonkam’s work is directly focused on both rare and common genetic diseases in vulnerable populations. His introduction to SCD was based on him witnessing its prevalence in his own environment. In the past, there were a lot of affected children in Africa who would die undiagnosed. There was also high morbidity of chronic, debilitating complications in adults because of SCD.
But over time, improved resources and fine-tuned diagnostics tools have led to increased identification of more children with SCD, resulting in improved life expectancy and access to treatment in high-income countries.
“By doing genetics, I might contribute to addressing some of these challenges.”
Inter-continental movements and global migration are also associated with increased SCD incidence – not only in South Africa but also in other areas of the world; some areas including those where the disease had not been prevalent previously.
Wonkam, the director of Genetic Medicine of African Populations (GeneMAP) at the FHS, realised that “by doing genetics, I might contribute to addressing some of these challenges.”
A move to UCT
Even with this background in mind, for Wonkam, moving into genetics at UCT was the result of a chance encounter. In 2006, in Addis Ababa while attending a meeting, he met the now-late Professor Bongani Mayosi, the past dean of the FHS; and Professor Raj Ramesar, the head of the Department of Pathology and Division of Human Genetics. The following year they met up again in Cairo. Professor Mayosi and Professor Ramesar persuaded Wonkam to move to the university in 2009.
This was coupled by Wonkam coming across an Open Day advert about UCT’s Division of Human Genetics while in Geneva. Having listened to the presenters, he was captivated and decided to specialise in medical genetics.
“Another dimension that strengthened my conviction [on this chosen path] was to specialise in a discipline that will make a difference in Africa, where very few geneticists existed. This remains the case today,” said Wonkam, who is also a full member of the Institute of Infectious Disease and Molecular Medicine based at the FHS.
A deeply embedded burden
SCD has global implications with approximately 305 800 babies born with it annually, and almost 75% of these births occurring on the continent. So for Wonkam, as an area of interest, this was an obvious choice.
He explained: “It’s the most common single gene disorder of humankind … There has not been enough investment in research for prevention and care of this condition, which is estimated that, without treatment, up to 50% of affected children in Africa will not see their fifth birthday.”
Driven by improving these odds, his work continues unabated – especially having recently been awarded a grant from the National Institutes of Health’s National Heart, Lung, and Blood Institute to help SickleInAfrica advance the SCD agenda on the continent by improving patient care and quality of life, through research and clinical care.
SickleInAfrica is a partnership between the Sickle Africa Data Coordinating Center (SADaCC) and the Sickle Pan-African Research Consortium. These entities have bases in South Africa, Tanzania, Nigeria, Mali, Zimbabwe, Zambia, Uganda and Ghana. The SADaCC, spearheaded by Wonkam (director and principal investigator) and Professor Nicky Mulder (co-investigator), was established at UCT.
Developing new therapies
The accolade recognises Wonkam’s work in describing novel variants in genes relevant for congenital hearing impairment in populations of African ancestry, in South Africa and various countries across the continent. This acknowledgement is also a hat-tip to his discovery of a set of gene variants that are key for long-term survival in SCD in Africa, exploration of which could open up new therapeutic routes. Wonkam has also introduced prenatal genetic diagnosis for SCD in both Cameroon and Cape Town, and so potentially helping parents better understand how to manage the disease.
Reflecting on receiving the award, Wonkam said: “It’s always good to have one’s work recognised, as it raises the profile and visibility of our research agenda. But I am simply the messenger. All this work would not be possible without the contribution of numerous patients and families, fellows and international collaborations, and strong support from funding agencies. I owe them a lot.”
Now able to return to his research at full throttle, having completed his DDR tenure, Wonkam said it was an excellent time that offered him the opportunity to contribute to restructuring the Research directorate.
“And now [I’m] pleased to be fully focused on my research agenda.”
Next frontier
Africa holds the genetic key to learnings that can be applied to populations across the globe – especially with the many genome variations on the continent which remain untapped.
“Due to the modern human originating from the continent, the next frontiers of genetic medicine rest in African genetics variations. A new scientific interest towards investigating these variants, to inform global genetic medicine, is anticipated,” Wonkam said.
“As the world recognises the need to invest more in research on African genomic variations, it is our hope that this will be done with African scientists. We must accelerate the path of education and training to be better prepared, otherwise Africa runs the risk of being left behind.”
 This work is licensed under a Creative Commons Attribution-NoDerivatives 4.0 International License.
This work is licensed under a Creative Commons Attribution-NoDerivatives 4.0 International License.
Please view the republishing articles page for more information.